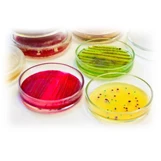
Chashka biologicheskaya (Petri)

Bosh sahifa / Tibbiy asbob-uskunalar / Laboratoriya jihozlari / Laboratoriya idishlari / Cokovijimalka promishlennaya J80 230/50/1 Robot Coupe, Fransiya
Cokovijimalka promishlennaya J80 230/50/1 Robot Coupe, Fransiya
AsosiyO‘xshash takliflarBoshqa korxonalardan o'xshash takliflarKo‘rilgan mahsulotlarFikr-mulohazalar



Mahsulotning ko'rinishi saytdagi rasmdan farq qilishi mumkin
Mahsulot haqida tafsilotlar
Bor
19 500 000 so'm / dona
Niva uquipment
Niva uquipmentdan o'xshash takliflar
Boshqa korxonalardan o'xshash takliflar
Ko‘rilgan mahsulotlar
Fikr-mulohazalar
Reyting 0, 0 ta sharh asosida